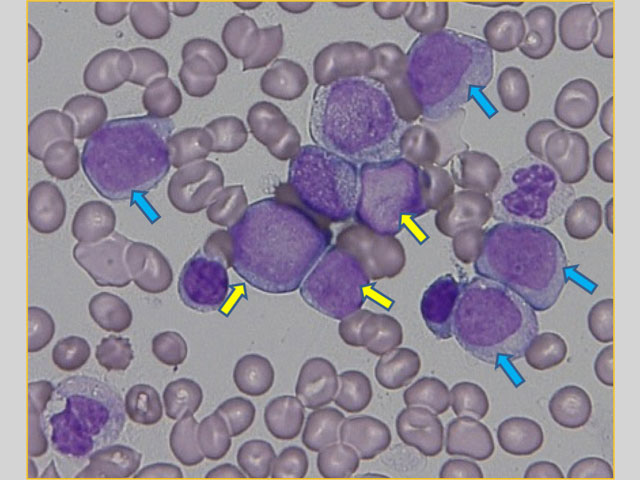

AML with myelodysplasia-related changes
[概要]
AML with myelodysplasia-related changesは、①骨髄異形成症候群(MDS)または骨髄異形成/骨髄増殖性腫瘍(MDS/MPN)からAMLに進展したもの、②MDSに関連した染色体異常(complex karyotypeやmonosomy 7など)をもつもの、③造血3系統の2系統以上に50%以上の異形成をもつもの、の3群からなるカテゴリーである。3つの群の2つないし3つが重複する症例もある。
比較的緩徐な臨床経過をとることが多く、血液検査では汎血球減少を示すことが多い。高齢者に多くみられ、小児では稀とされてきたが、②群と③群は小児でも一定の頻度で認められる。
NPM1変異やbiallelic CEBPA変異をもつ症例はこのカテゴリーから除かれる。また、多系統の異形成を認めても、t(6;9)などのAML with recurrent genetic abnormalitiesに含まれる核型であれば、AML with recurrent genetic abnormalitiesに分類される。なお、deletion 9qはt(8;21)やNPM1,biallelic CEBPA変異のAMLでしばしば認められることからWHO分類2017年版では除外された。
[症例1]
11歳、男性。2ヶ月前より顔色不良を認めていた。1週間前より労作時に息切れを感じるようになり受診した。既往歴、家族歴に特記すべきことなし。身体所見では顔色不良および眼瞼結膜に貧血を認める。
[末梢血検査所見]
| WBC | 2100/μL |
| Blast | 5% |
| Seg | 5% |
| Lympho | 68% |
| Mono | 22% |
| RBC | 215万/μL |
| Hb | 6.3g/dL |
| Ht | 20.0% |
| MCV | 93.0fL |
| PLT | 13.7万/μL |
| Ret | 0.6% |
[骨髄形態診断]
骨髄は軽度低形成、顆粒球系優位で、巨核球系は著減している。
骨髄芽球を25.6%、単芽球を13.0%認める、前単球を2.0%認める。芽球相当の細胞の合計は40.6%である。骨髄芽球は中型、細胞質は狭小、好塩基性の細胞質にアズール顆粒を認める。核網は繊細で、1つあるいは2,3個の核小体を有する。単芽球は大型、比較的豊富な細胞質をもち少数のアズール顆粒を認める。核網は繊細で、核小体が目立つ。また、単球を8.9%認める。
MPO染色は弱陽性(7%)、CAE染色は弱陽性(12%)、NSE染色は陽性(49%)である。NaFで阻害される。顆粒球系の50%以上に低顆粒、偽ペルゲル核異常、赤芽球系の50%以上に巨赤芽球様変化、核辺縁不整の異形成を認める。巨核球系は認めず異形成の評価は困難である。
以上から、AML with multilineage dysplasiaが疑われる骨髄所見である。
[骨髄血細胞表面マーカー]
| マーカー | 陽性率(%) |
|---|---|
| MPO | 7 |
| CD117 | 64 |
| CD13 | 98 |
| CD15 | 33 |
| CD33 | 97 |
| CD64 | 40 |
| CD65 | 86 |
| HLA-DR | 98 |
| CD34 | 74 |
| CD56 | 95 |
| CD7 | 95 |
[染色体・遺伝子検査]
[染色体]G分染法(PHA無添加24・48時間培養)
46,XY,der(5)t(5;12)(q13;q13)ins(5;?)(q13;?),del(11)(p?),del(12)(q13)[15]
46,XY[5]
[FLT3-ITD]
検出されず
[NPM1、CEBPA]
変異を認めず。
[解説]
形態学から骨髄異形成変化を伴うAMLと診断するためには2系統以上で50%以上の異形成を認めることが必要条件である。本症例では、骨髄系異形成(低顆粒好中球、偽ペルゲル核異常)、赤芽球系異形成(巨赤芽球様変化、核辺縁不整)をそれぞれ50%以上に認め、この条件を満たしている。
また、5番染色体、11番染色体、12番染色体に異常を持ついわゆるcomplex karyotypeであったことも骨髄異形成変化を伴うAMLと診断する条件を満たしている。
さらに、NPM1、CEBPAの変異は確認されず、骨髄異形成変化を伴うAMLと確定された。
[症例2]
4歳、男性。8日前より発熱し、インフルエンザ迅速検査陽性で抗ウイルス薬を使用し翌日に解熱した。2日前より再度発熱し、前医を受診。歯肉腫脹を認め血液検査が行われた。既往歴、家族歴に特記すべきことなし。身体所見では顔色不良、眼瞼結膜貧血様。歯肉腫脹あり。
[末梢血検査所見]
| WBC | 7700/μL |
| Blast | 57% |
| Seg | 32% |
| Lympho | 7% |
| Mono | 4% |
| RBC | 255万/μL |
| Hb | 8.8g/dL |
| Ht | 24.8% |
| PLT | 11.2万/μL |
| Ret | 1.1% |
[骨髄形態診断]
骨髄は過形成、赤芽球系が優位で、巨核球系は増加している。芽球を32.6%認める。芽球は中型〜大型、細胞質は淡灰青色で比較的狭く、円形の核を有し核網繊細である。一部湾入を有し、大型の核小体がある。
芽球には赤血球やリンパ球の貪食像を認める。
MPO染色は陽性(9%)、CAE染色は弱陽性(6%)、NSE染色は陰性である。
顆粒球系の50%以上に偽ペルゲル核異常や低顆粒・無顆粒好中球、巨大好中球の異形成を認める。赤芽球系には明らかな異形成を認めない。巨核球系の50%以上に、微小巨核球、単核巨核球の異形成を認める。
以上から、AML with multilineage dysplasia が示唆されるが、芽球の血球貪食像が特徴的な症例である。
[骨髄血細胞表面マーカー]
| マーカー | 陽性率(%) |
|---|---|
| CD13 | 85 |
| CD33 | 92 |
| CD117 | 80 |
| CD64 | 21 |
| CD65 | 22 |
| MPO | 23 |
| CD34 | 89 |
| HLA-DR | 83 |
| CD56 | 95 |
[染色体・遺伝子検査]
[染色体]G分染法(PHA無添加24・48時間培養)
46,XY,t(2;11)(p21;p15),t(16;21)(p11.2;q22)[13]/46,XY[7]
[キメラ遺伝子スクリーニング]
FUS-ERG 8800コピー/μg RNA
[FLT3-ITD]
検出されず
[解説]
.t(16;21)(p11;q22);FUS-ERG AMLは若年者に発症する予後不良の白血病で東アジアからの報告例が多い。FAB分類上はM3,M6以外の様々な病型が報告されているが、M2、M7の報告例が多い。
t(8;16)(p11;p13);KAT6A-CREBBP(MOZ-CBP)と並んで芽球の血球貪食像が特徴的に認められる。本症例のように異形成を認める症例も報告されている。また骨髄の好酸球増加を呈する症例も報告されているが本症例では見られなかった。
細胞表面マーカーは一般的なAMLに一致した結果を示すが、CD34、CD56が陽性を示す症例が多い。
参考文献
- Kinoshita A,Miyachi H,Matsushita H,et al.Acute myeloid leukaemia with myelodysplastic features in children:a report of Japanese Paediatric Leukaemia/Lymphoma Study Group Br J Haematol.167:80-6. 2014
- Noort S,Zimmermann M,Reinhardt D,et al.Prognostic impact of t(16;21)(p11;q22) and t(16;21)(q24;q22) in pediatric AML:a retrospective study by the I-BFM Study Group.Blood.132:1584-1592. 2018
Copyright 2021 株式会社 ビー・エム・エル All rights reserved.
このページ表示されているすべての情報(画像、図、表、文章等)の無断転載を禁じます。